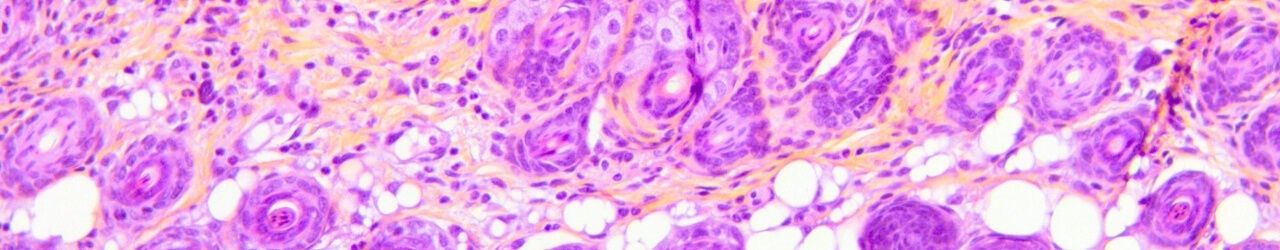

in vivo pharmacology models in Dermatology
For more than 20 years, the SKINAXIS team has been providing preclinical dermatology models that reproduce the pathophysiological alterations observed in human clinical settings. SKINAXIS has also developed unique expertise in evaluating innovations in regenerative medicine (skin grafts, organoid grafts, cellular and acellular substitutes) and medical devices for wound healing.
The translational value of SKINAXIS models is demonstrated by the large number of therapeutic innovations whose benefits were successfully confirmed during clinical trials undergone by our clients.
The effects of your compounds and therapeutic innovations can be evaluated through complementary, multi‑scale approaches, including proprietary scoring systems, skin barrier function measurements, biomarker analyses, and behavioral assessments relevant to inflammatory skin diseases such as psoriasis, atopic dermatitis, and eczema, which induce pruritus and modify locomotor behavior.
Skin Inflammatory Diseases
Skin inflammatory diseases are characterized by abnormal immune activation, leading to erythema, pruritus, and functional impairment of the skin barrier. Our platform provides predictive models and high‑performance analytical tools to screen and evaluate your lead candidates and support dose and regimen optimization to maximize therapeutic outcomes.
Psoriasis – Imiquimod Model
Repeated topical applications of Imiquimod in mice progressively induce inflammation (erythema), edema, and plaque‑forming scaling, mimicking psoriasis. This model integrates in situ measurements (TEWL, dermoscopy, scoring…), behavioral assessments, serum biomarker analyses (IL-17, IL-23, IL-6…), and histological/immunohistochemical evaluations. It offers high predictive value for clinical success and constitutes a robust tool to evaluate therapeutic efficacy.


Atopic Dermatitis- DNCB model
Repeated topical applications of DNCB in mice progressively induce inflammation (erythema), edema, erosion, and desquamation, modeling atopic dermatitis. This model includes in situ measurements (TEWL and scoring), behavioral assessments, serum biomarker analyses (IL-33, IgE, histamine…), and histology/immunohistochemistry. It offers high predictive value for clinical success and constitutes a robust tool to evaluate therapeutic efficacy.
Atopic Eczema (Pruritus) – MC903 model
Repeated topical applications of MC903 in mice induce marked pruritus associated with progressive inflammation (erythema), edema, and desquamation, modeling atopic eczema. This model integrates in situ measurements (TEWL, dermoscopy, scoring…), behavioral assessments, and serum cytokine analyses. It offers high predictive value for clinical success and constitutes a robust tool to evaluate therapeutic efficacy.
Chronic Skin Inflammation
Repeated topical applications of TPA in mice induce long‑lasting inflammation modeling chronic cutaneous inflammation. This model integrates in situ measurements (TEWL, dermoscopy, scoring…), behavioral assessments, serum cytokine analyses (IL-1β, IL-6, TNF-α…), and histology/immunohistochemistry. This generalist model offers high predictive value for clinical success and constitutes a robust tool to evaluate therapeutic efficacy.
Hyperkeratosis
Repeated topical applications of TPA in mice induce skin dryness, stratum corneum thickening, and desquamation, modeling hyperkeratosis commonly observed in warts.
This model integrates in situ measurements (TEWL, dermoscopy and scoring) and histological/immunohistochemical analyses. It offers high predictive value for clinical success and constitutes a robust tool to evaluate therapeutic efficacy.
Actinic Keratosis
Semi‑chronic UVB exposure in mice induces benign cancerous lesions producing small rough plaques at the skin surface, modeling actinic keratosis. This model integrates in situ measurements (TEWL, dermoscopy, scoring…). It offers high predictive value for clinical success and constitutes a robust tool to evaluate therapeutic efficacy.
UVB‑Induced Skin Cancer
Chronic UVB exposure induces malignant skin lesions marked by tumor formation at the skin surface, modeling UVB‑induced skin cancer. This model integrates in situ measurements (TEWL, dermoscopy, scoring…). It offers high predictive value for clinical success and constitutes a robust tool to evaluate therapeutic efficacy.
Pain upon skin application
Following skin injury, cutaneous pain can result from direct nociceptor activation or inflammation that activate nociceptive pathways. This model evaluates acute tolerance to topical formulation application under physiologically relevant conditions.
Wound Healing Models
Wound healing is a complex biological process involving cellular, molecular, and tissue‑level events aimed at restoring skin integrity. Our platform supports the evaluation of acute and chronic wound healing using predictive models and high‑performance analytical tools to evaluate your lead candidates or medical devices.
Incisional Skin Wound
Incisional wounds in healthy or diabetic mice or rats mimic the healing of acute wounds.
This model integrates in situ assessments throughout the healing process (scoring of several parameters). It offers high predictive value for clinical success and constitutes a robust tool to evaluate therapeutic efficacy.


Full excisional Skin Wound
Full excisional wounds in healthy or diabetic mice or rats mimic the healing of acute wounds after tissue excision.
This model integrates in situ assessments throughout the healing process (TEWL, dermoscopy, scoring…). It offers high predictive value for clinical success and constitutes a robust tool to evaluate therapeutic efficacy.
Ischemic Ulceration
Ischemia‑induced ulceration models chronic wounds healing in healthy or diabetic mice or rats after important tissue loss.
This model integrates in situ assessments throughout the healing process (TEWL, dermoscopy, scoring…). It offers high predictive value for clinical success and constitutes a robust tool to evaluate therapeutic efficacy.
Superfical Wound (Abrasion)
Abrasion‑induced wounds model superficial traumatic lesions in mice and rat.
This model integrates in situ assessments throughout the healing process (photos, dermoscopy, scoring…). It offers high predictive value for clinical success and constitutes a robust tool to evaluate therapeutic efficacy.
Blister Model
Heat‑ and pressure‑induced blister model to assess superficial wound healing in mice.
This model integrates in situ assessments throughout the healing process (TEWL, dermoscopy, scoring…). It offers high predictive value for clinical success and constitutes a robust tool to evaluate therapeutic efficacy.
Skin grafting
Circular Skin Graft
Circular excisional wounds of customizable diameter in immunocompetent or immunodeficient in mice and rats modeling chronic wound healing.
This model integrates in situ assessments throughout the healing process (TEWL, dermoscopy, scoring…). It offers high predictive value for studying host-substitute interactions and constitutes a robust tool to evaluate therapeutic efficacy for wound healing applications.
Square Skin Graft
Square excisional wounds of customizable size in immunocompetent or immunodeficient in mice and rats modeling chronic wound healing.
This model integrates in situ assessments throughout the healing process (TEWL, dermoscopy, scoring…). It offers high predictive value for studying host-substitute interactions and constitutes a robust tool to evaluate therapeutic efficacy for wound healing applications.
Flap Graft
Flap graft procedures allow evaluation of skin substitutes under anaerobic physiological conditions in immunocompetent or immunodeficient in mice and rats for wound healing.
It offers high predictive value for studying host-substitute interactions and constitutes a robust tool to evaluate therapeutic efficacy for wound healing applications.
Chimney Graft Model
Grafting with an insert allows evaluation of skin substitutes under aerobic conditions in immunocompetent or immunodeficient in mice and rats model chronic wound healing.
This model integrates in situ assessments throughout the healing process (TEWL, dermoscopy, scoring…). It offers high predictive value for studying host-substitute interactions and constitutes a robust tool to evaluate therapeutic efficacy for wound healing applications.
Dermal Toxicity (Non-GLP)
Dermal toxicity refers to the ability of a substance to induce local skin damage and/or systemic toxicity following transcutaneous absorption. Our platform enables non‑GLP acute, subchronic, and chronic dermal toxicity evaluations to de‑risk your hit selection at an early stage.
Acute Dermal Toxicity (OECD 402)
Assesses local or systemic adverse effects after a single dermal exposure. The study is performed according to OECD 402 guideline within an ISO 9001‑certified quality framework. Ideal for early de‑risking of your drug candidates prior to GLP safety studies.
Subchronic Dermal Toxicity (OECD 410)
Assesses local or systemic adverse effects after repeated dermal exposure (4 weeks). The study is performed according to OECD 410 guideline within an ISO 9001‑certified quality framework. Ideal for early de‑risking of your drug candidates prior to GLP safety studies.
Chronic Dermal Toxicity (OECD 411)
Assesses local or systemic adverse effects after repeated dermal exposure (13 weeks). The study is performed according to OECD 411 guideline within an ISO 9001‑certified quality framework. Ideal for early de‑risking of your drug candidates prior to GLP safety studies.
Pharmacokinetics (PK) and neuro-PK
Our pharmacokinetic studies are based on flexible kinetic models tailored to your drug candidate. We analyze standard biological matrices (plasma, serum, CSF) as well as key organs or anatomical regions to accurately characterize your molecule’s tissue exposure. These robust and customizable approaches provide a solid foundation for your preclinical decisions.
PK model
We offer studies tailored to your PK and Neuro-PK needs, covering various administration routes (subcutaneous, intraperitoneal, intravenous, oral, intranasal, etc.) in both acute and chronic treatment paradigms. The bioavailability of your molecules is quantified across different compartments—including blood, brain, cerebrospinal fluid, or any other tissue of interest. This approach provides reliable data to support decision-making and accelerate the development of your therapeutic candidates.
Available in mice, rats, and pigs.
Other Inflammatory Diseases
Inflammatory diseases are characterized by recruitment and activation of inflammatory cells and the formation of diverse lesions affecting multiple organs. Our platform enables direct evaluation of candidates on target organs with predictive models and high‑performance analytical tools to screen and evaluate your lead candidates and support dose and regimen optimization to maximize therapeutic outcomes. This allows you to prioritize your leads with the highest translational potential.
Colonic Ulceration (TNBS)
A single intrarectal administration of TNBS induces colonic ulceration in rats resulting from the inflammatory aggression generated by TNBS. In addition to classic histological and biomarker assessments, this model integrates exclusive measurements by colonoscopy and behavioral scoring.
It offers high predictive value for clinical success and constitutes a robust tool to evaluate the therapeutic efficacy of your candidates.
Cystitis (Cyclophosphamide)
One or several systemic administrations of cyclophosphamide induce acute or chronic bladder inflammation in rats, resulting from the urinary accumulation of toxic metabolites generated by the metabolic activation of cyclophosphamide.
In addition to classic histological and biomarker assessments, this model integrates exclusive behavioral analyses. It offers high predictive value for clinical success and constitutes a robust tool to evaluate the therapeutic efficacy of your candidates.
Liver fibrosis (Phenobarbital/CCl4)
Repeated escalating‑dose administrations of carbon tetrachloride (CCl4) in rats previously exposed to phenobarbital induce hepatic toxicity that generates inflammation progressing toward hepatic fibrosis.
In addition to classic histological and biomarker assessments, this model integrates exclusive behavioral analyses. It offers high predictive value for clinical success and constitutes a robust tool to evaluate the therapeutic efficacy of your candidates.
Benign Prostatic Hyperplasia (Testosterone)
Repeated testosterone administration induces progressive inflammation leading to benign prostate enlargement, namely benign prostatic hyperplasia, in male rats.
This model offers a high predictive value for clinical success and constitutes a robust tool to evaluate therapeutic efficacy.
Diarrhea (Castor Oil)
A single intragastric administration of castor oil induces acute intestinal inflammation and diarrhea.
In addition to classic histological and biomarker assessments, this model integrates exclusive behavioral scoring. It offers high predictive value for clinical success and constitutes a robust tool to evaluate the therapeutic efficacy of your candidates.
High-Content Imaging
Brain‑on‑Chip platform
Small and Large Animal Facilities
Preclinical Medical Imaging
Immunohistochemistry, Immunofluorescence, and Histology
Immunoassays
The effects of your molecules can be evaluated through complementary and multi-scale approaches.
